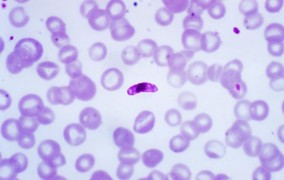

Noticias
-
Fotónica cuántica y no lineal es tema de la Escuela São Paulo de Ciencia Avanzada
18-06-2026El evento se realizará entre el 16 y el 27 de noviembre, en Campinas; inscripciones abiertas hasta el 30 de junio -
La alianza científica entre Brasil y Argentina resiste las crisis y la fragmentación geopolítica
18-06-2026Durante la 3.ª Conferencia FAPESP 2026, Ernesto Mané Jr., jefe del Sector de Ciencia, Tecnología e Innovación de la Embajada de Brasil en Buenos Aires, señala caminos para mantener activa la colaboración entre ambos países. -
El cambio climático eleva la producción de soja, pero empeora la calidad del grano
18-06-2026Utilizando modelado con IA alimentado por datos validados experimentalmente, investigadores de la Universidad de São Paulo prevén el impacto simultáneo de altas temperaturas, sequía y aumento de CO₂ -
Marcador inédito utiliza tomografía para perfeccionar el pronóstico del cáncer gástrico
18-06-2026Científicos de la Universidad Estatal de Campinas identificaron una variable que combina datos de la radiodensidad de la grasa visceral y del músculo, capaz de identificar a los pacientes con mayor riesgo de evolución desfavorable de la enfermedad -
La capacidad de acumular toxinas de la dieta evolucionó de forma gradual en las ranas venenosas
18-06-2026Investigadores sugieren la existencia de al menos cuatro fenotipos de sapos, que representan etapas evolutivas relacionadas con el secuestro de alcaloides, toxinas presentes en insectos que son utilizadas por algunas líneas evolutivas de anfibios anuros para combatir depredadores y patógenos -
Investigadores identifican un potencial blanco terapéutico contra el cáncer
18-06-2026Una molécula presente en la superficie de las células podría abrir el camino para nuevas terapias contra la progresión tumoral -
El virus Oropouche ya habría infectado a más de 5 millones de personas en Brasil, sugiere estudio
18-06-2026Se estima que la cifra alcanza los 9,4 millones de casos en toda América Latina y el Caribe desde la década de 1960, según artículos publicados por revistas del Grupo Nature. Los autores advierten que las estrategias de combate contra el vector, el jején, deben ser diferentes de las utilizadas contra el Aedes -
El organismo aprovecha poco de los minerales de las nueces, apunta un estudio que simuló la digestión humana
11-06-2026Una investigación realizada en la Universidad Federal de São Paulo mostró que el organismo humano consigue liberar solamente una fracción del cobre y del manganeso presentes en la nuez de Brasil y en la nuez de marañón -
Hongo patógeno transmitido por arañazos de gatos domésticos está presente en animales de la fauna silvestre
11-06-2026Investigadores detectaron especies patógenas de Sporothrix en órganos internos de mamíferos, aves y reptiles muertos por atropellamiento en carreteras de Brasil; el estudio revela un nuevo reservorio para estos hongos y alerta sobre la necesidad de vigilancia -
Material aumenta la vida útil y prolonga la liberación de hongo utilizado como bioinsecticida
11-06-2026El encapsulamiento de Beauveria bassiana con un biopolímero a base de celulosa y aluminio aumentó del 69% al 85 % la viabilidad del hongo después de cinco meses de almacenamiento; esta alternativa más sostenible permite que el bioinsecticida se libere de forma prolongada y reduzca la necesidad de nuevas aplicaciones -
La inteligencia artificial convierte las cámaras de seguridad en sistemas de monitoreo activo
11-06-2026Tecnología de aprendizaje autónomo desarrollada por una startup apoyada por la FAPESP filtra imágenes irrelevantes y reduce las fallas humanas en la vigilancia -
Molécula antiinflamatoria muestra potencial contra el Parkinson en estudio con ratones
11-06-2026En un experimento, el péptido Ac2-26 protegió a las neuronas de la muerte celular característica de la enfermedad; el estudio también demostró diferencias entre machos y hembras en la progresión y la protección frente a la enfermedad -
Investigación muestra que las áreas húmedas del Cerrado almacenan más carbono que los bosques de la Amazonía
11-06-2026Estas regiones son capaces de almacenar hasta 1.200 toneladas de carbono por hectárea, el equivalente a cerca de seis veces el almacenamiento de biomasa promedio de la selva tropical -
La nanotecnología brasileña permite tratar enfermedades de la piel con precisión
11-06-2026Grupo de la Universidad de São Paulo produce nanopartículas de cristal líquido con moléculas terapéuticas para reducir la inflamación en enfermedades como la psoriasis y el vitiligo; los avances fueron presentados en la FAPESP Week Londres -
Estudio revela 45 nuevas toxinas producidas por bacterias asociadas a infecciones alimentarias
04-06-2026Las búsquedas se realizaron con herramientas computacionales que analizaron el material genético de 6.165 muestras de 149 tipos diferentes de la subespecie Salmonella enterica -
Nuevo centro apoyado por la FAPESP busca hacer las ciudades más resilientes frente a las inundaciones
04-06-2026El CCD Ciudades Resilientes a Inundaciones fue inaugurado en el Instituto de Investigaciones Tecnológicas y reunirá a gobierno, universidades y empresas en la búsqueda de soluciones al problema -
Nuevas especies de polillas son descritas en homenaje a orixás
04-06-2026Con distribución en la Amazonía, el Pantanal y la Mata Atlántica, fueron diferenciadas a partir de lo que se conocía como una sola especie mediante la integración de análisis morfológicos, datos moleculares y de interacción con plantas hospederas -
Biomaterial elaborado a base de látex de yaca es un tratamiento prometedor contra la periodontitis
04-06-2026Con extracto de cáscara de granada y simvastatina, el producto demostró ser eficaz para combatir la infección, la inflamación y la pérdida de tejido periodontal provocadas por la enfermedad -
Investigadores buscan soluciones para evitar el colapso de la salud mental de los docentes de educación básica
04-06-2026Seminario internacional promovido por el Centro de Ciencia para el Desarrollo de la Educación Básica reunió a especialistas de ocho países -
FAPESP busca impulsar la colaboración científica entre São Paulo y Reino Unido
04-06-2026La Fundación promueve por tercera vez en Inglaterra el simposio FAPESP Week, con el objetivo de consolidar y ampliar alianzas en áreas estratégicas como la transición energética y la inteligencia artificial -
Estudio muestra que mutaciones en el gen TP53 afectan la respuesta al tratamiento del cáncer de pulmón
04-06-2026Una investigación analizó muestras tumorales de más de mil pacientes atendidos en la red nacional de salud pública de Brasil -
Investigadores mapean iniciativas en la Amazonía que inspiran el futuro de la innovación
28-05-2026Una misión científica en la región, realizada por iniciativa de un CEPID apoyado por la FAPESP, muestra cómo la integración de deep techs con saberes locales puede contribuir a regenerar ecosistemas y producir soluciones globales -
Un estudio dilucida las condiciones para la riqueza de especies de anfibios en islas marinas
28-05-2026Análisis de datos de más de 5 mil territorios y 1.924 especies de sapos, ranas y ranitas arborícolas muestra que dos de las principales teorías sobre biodiversidad de plantas, aves y mamíferos en estos hábitats no explican por sí solas la riqueza de anfibios anuros -
La temperatura en la ciudad de São Paulo aumenta más que el promedio global
28-05-2026Fenómeno relacionado con la sustitución de la vegetación por materiales como asfalto, concreto y mampostería agrava el calentamiento, señala investigador de la Universidad de São Paulo en un evento promovido por la FAPESP y la NWO -
Un estudio explica por qué las galaxias más masivas del Universo joven dejaron de formar estrellas de manera precoz
28-05-2026Un modelo señala la ocurrencia de fusiones entre galaxias, describe cómo esto generó intensos brotes de producción estelar y formación de agujeros negros supermasivos, y sostiene que la acción de los núcleos activos bloqueó el suministro de materia prima para nuevas estrellas -
Las sequías más prolongadas y los cambios en las lluvias ya ocurren en la Amazonía, señalan investigaciones
28-05-2026Liderados por científicos brasileños, estudios recientemente publicados indican la prolongación de la estación seca de cuatro hasta seis meses, con un aumento del déficit hídrico superior a 150 milímetros; los trabajos constituyen una alerta para 2026 y 2027, cuando se prevé un “súper El Niño” -
Escuela São Paulo de Ciencia Avanzada en FoodOmics abre inscripciones
21-05-2026Evento de la Universidad Estatal de Campinas promueve la comprensión del potencial de las tecnologías ómicas en las áreas de ciencia, ingeniería, tecnología de alimentos y nutrición -
Los eventos climáticos extremos amenazan los ecosistemas fluviales
21-05-2026Una investigación indica cómo los ríos de distintas regiones del planeta atraviesan transformaciones profundas que superan su capacidad de resiliencia -
Una investigación traza una estrategia de protección del cacao amazónico contra la escoba de bruja
21-05-2026Un estudio identifica cultivares que mantienen alta productividad y resiliencia frente al ataque de la escoba de bruja, lo que abre el camino para un cultivo más sostenible en la región -
Una investigación contesta el supuesto efecto antiinflamatorio de la creatina
21-05-2026Una revisión de estudios realizada por investigadores de la Universidad Estatal Paulista confirmó la seguridad del suplemento pero no encontró efectos significativos sobre marcadores inflamatorios en el organismo -
El virus Sabiá circula en Brasil desde hace 142 años y está modificándose, señala un estudio
21-05-2026Investigadores de un centro apoyado por la FAPESP desarrollaron un nuevo método e identificaron la infección en dos pacientes que fallecieron por síndrome hemorrágico agudo y neurológico en São Paulo, en 2019 y 2020 -
La duración de la depresión puede modular cómo la gravedad de la enfermedad altera el cerebro
21-05-2026Investigadores de la Universidad de São Paulo y de Oxford muestran que la duración del trastorno, además de la gravedad de los síntomas, está asociada a diferencias en las conexiones funcionales cerebrales, lo que puede abrir camino a tratamientos personalizados -
Científicos descubren cómo la obesidad paterna afecta el metabolismo de los hijos
21-05-2026Experimentos con roedores muestran que moléculas presentes en los espermatozoides “transmiten” la disfunción metabólica a los descendientes, que se vuelven prediabéticos. El fenómeno es reversible con la pérdida de peso antes de la concepción -
Los indígenas sudamericanos son diversos y descienden de una tercera ola migratoria
21-05-2026Estudio con genomas completos de todo el continente reconstruye una historia más detallada del poblamiento del continente; el estudio fue portada de Nature -
Electrosíntesis sostenible permite producir aminas directamente a partir del nitrógeno del aire
14-05-2026Investigación conducida por un centro apoyado por la FAPESP abre el camino para la producción de insumos químicos ampliamente utilizados en la industria, como en medicamentos y cosméticos, donde actúan como ingredientes activos o estabilizantes -
Sensores biodegradables acoplados a plantas detectan pesticidas en 3 minutos
14-05-2026Fabricados con material atóxico de origen vegetal, los dispositivos también pueden monitorear biomarcadores, enfermedades y niveles de nutrientes en las plantas -
Microfósiles interpretados como rastros de animales eran en realidad algas y bacterias
14-05-2026Nuevas evidencias y reanálisis de material de 540 millones de años con técnicas avanzadas de imagen descartan la interpretación de que fueran gusanos o pequeños animales oceánicos -
Educación básica avanza, pero las desigualdades son obstáculos estructurales, afirma Ivan Siqueira
14-05-2026La evaluación fue realizada por el profesor de la Universidad Federal de Bahía Ivan Siqueira durante la 2ª Conferencia FAPESP 2026; el especialista también discutió los límites del modelo actual, la necesidad de criterios objetivos en las políticas educativas y los impactos de la inteligencia artificial en la enseñanza -
Genes vinculados a la comunicación entre neuronas aparecen alterados en células de defensa de pacientes con depresión
14-05-2026El mapeo genético refuerza el carácter sistémico de la enfermedad y abre camino al desarrollo de análisis de sangre capaces de detectarla -
Incluso en bajas concentraciones en el aire, el material particulado aumenta las hospitalizaciones por enfermedades renales
14-05-2026En diez años, los niveles de este tipo de contaminación en la ciudad de São Paulo (Brasil) llegaron a superar en más de cuatro veces el límite recomendado por la Organización Mundial de la Salud -
Método calcula trayecto entre la Tierra y la Luna más eficiente que todos los ya descritos
14-05-2026Investigación apoyada por la FAPESP simuló 30 millones de rutas diferentes y trazó un itinerario que demanda un consumo de combustible 58,80 metros por segundo menor que el más económico -
Tecnología brasileña ayuda a la NASA a evaluar riesgos para la salud de astronautas en misión a la Luna
14-05-2026La agencia espacial de Estados Unidos utilizó un dispositivo desarrollado por una startup apoyada por la FAPESP para monitorear los patrones de sueño, la actividad física y las interacciones de los astronautas de la misión Artemis 2 -
En un experimento, truchas amarillas crecen más que las de línea salvaje
07-05-2026El desempeño del fenotipo, resultado del cruce con una línea albina, fue superior a lo que se suele encontrar en cultivos de la especie de clima templado, abriendo camino para el desarrollo de nuevos productos pesqueros -
Material barato comprime la luz y abre camino para microcircuitos fotónicos en la banda de terahercios
07-05-2026Un estudio muestra que el yoduro de plomo puede sostener fonón-polaritones, permitiendo confinar la radiación a escala nanométrica y viabilizando nuevos dispositivos de transmisión de datos -
Nuevo dinosaurio de cuello largo encontrado en Maranhão era pariente cercano de una especie europea
07-05-2026Dasosaurus tocantinensis medía cerca de 20 metros de longitud y vivió hace aproximadamente 120 millones de años; su especie más cercana vivió en la actual España -
Sistemas atmosféricos controlan las lluvias y el transporte de nutrientes desde África hasta la Amazonía
07-05-2026Un estudio indica que eventos como masas de aire frío en el hemisferio norte alteran el paso de aerosoles sobre el Atlántico que ayudan a nutrir los suelos de la selva; se creía que la influencia provenía del cambio en la dirección de los vientos -
Científicos utilizan ultrasonido para hacer estallar virus de la influenza A y de la COVID-19 sin dañar células humanas
07-05-2026El uso de ondas de alta frecuencia abre el camino para un nuevo tratamiento contra otras infecciones virales, como dengue, zika y chikungunya -
Brasileños obtienen el primer cerdo clonado de América Latina para xenotrasplante
07-05-2026Proyecto llevado a cabo en la Universidad de São Paulo con apoyo de la FAPESP busca garantizar que el país disponga de tecnología propia y no dependa de importaciones para realizar xenotrasplantes en el sistema público -
Aplicación de melatonina aumenta la eficacia del trasplante de tejido ovárico autólogo, revela estudio
30-04-2026Investigación realizada con ratones mostró que la sustancia mejoró la viabilidad de los injertos, material que preserva la fertilidad de pacientes oncológicos jóvenes -
Estudio comprueba la acción de planta medicinal contra el virus SARS-CoV-2
30-04-2026Trabajo coordinado por profesor de la Universidad de São Paulo mostró que una sustancia extraída de las hojas de Copaifera lucens Dwyer combate el microorganismo causante de la COVID-19 en múltiples frentes
Lo más visto
-
El organismo aprovecha poco de los minerales de las nueces, apunta un estudio que simuló la digestión humana
11-06-2026
-
Investigación muestra que las áreas húmedas del Cerrado almacenan más carbono que los bosques de la Amazonía
11-06-2026
-
Nuevo dinosaurio de cuello largo encontrado en Maranhão era pariente cercano de una especie europea
07-05-2026
-
El cambio climático eleva la producción de soja, pero empeora la calidad del grano
18-06-2026
-
‘Andamio’ de grafeno recluta células óseas y ayuda al organismo a regenerar fracturas
02-04-2026
-
En un experimento, truchas amarillas crecen más que las de línea salvaje
07-05-2026
-
La inteligencia artificial convierte las cámaras de seguridad en sistemas de monitoreo activo
11-06-2026
-
Una investigación combina sabor y valor nutricional en el chocolate amazónico
19-03-2026
-
Estudio alerta sobre los riesgos nutricionales del uso prolongado del medicamento omeprazol
05-02-2026
-
Científicos utilizan ultrasonido para hacer estallar virus de la influenza A y de la COVID-19 sin dañar células humanas
07-05-2026